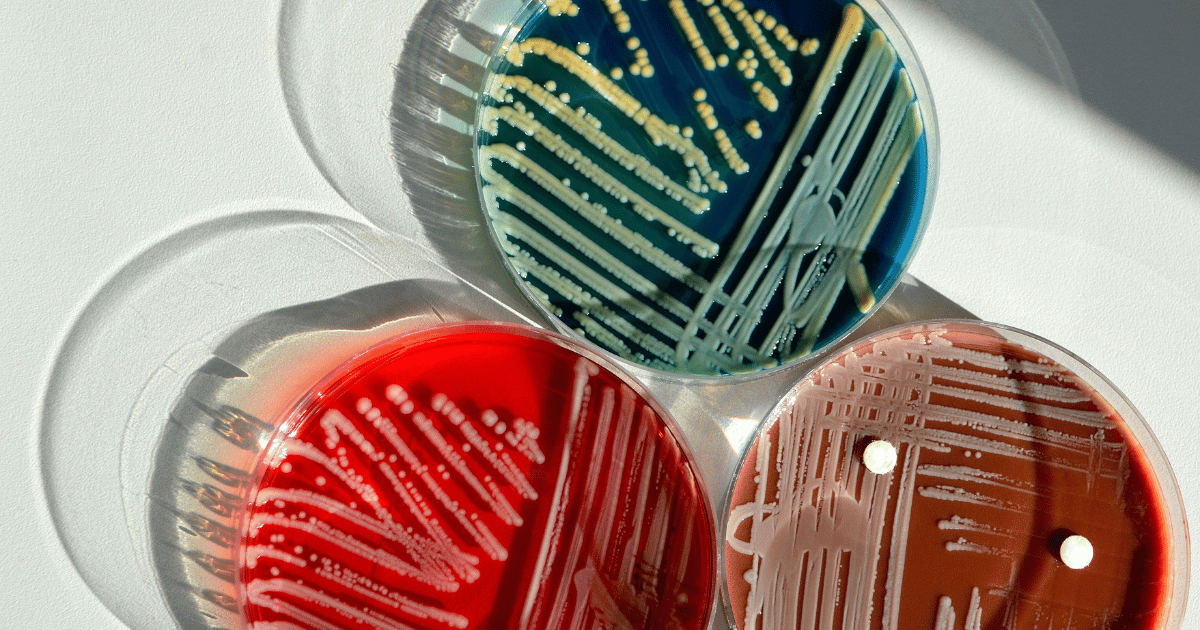

How Bacterial Filters Contribute to Sustainable Environments
Bacterial filters are essential for encouraging environmentally friendly activities and maintaining public health safety in a time when sustainability and health are of the utmost
Bacterial filters are essential for encouraging environmentally friendly activities and maintaining public health safety in a time when sustainability and health are of the utmost
First patent for ‘Infusion device with air intake’ registered by GVS
Discover how EG TECH System Sdn Bhd can support your next construction project with our advanced aluminum formwork solutions. Contact us today to learn more about our products and services, or request a consultation with our expert team.
EG Tech System Sdn Bhd (1511216-P)
© 2025 EG Tech System. All rights reserved.
We are always here for you! send us a mail now if you have any questions!